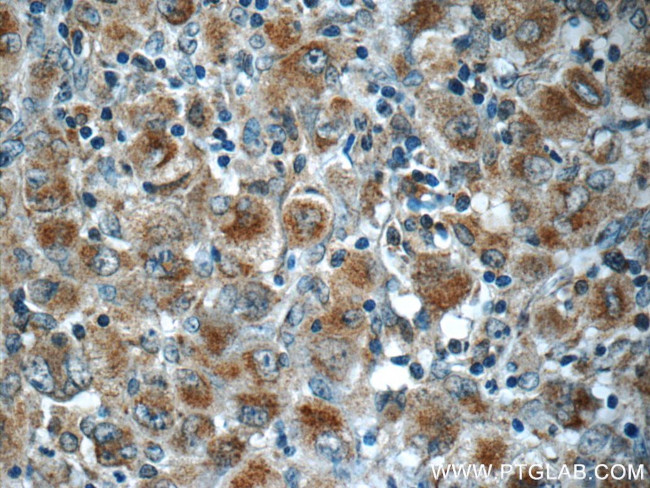
RNF213 Antibody in Immunohistochemistry (Paraffin) (IHC (P))

Search
Proteintech
RNF213 Polyclonal Antibody
{{$productOrderCtrl.translations['antibody.pdp.commerceCard.promotion.promotions']}}
{{$productOrderCtrl.translations['antibody.pdp.commerceCard.promotion.viewpromo']}}
{{$productOrderCtrl.translations['antibody.pdp.commerceCard.promotion.promocode']}}: {{promo.promoCode}} {{promo.promoTitle}} {{promo.promoDescription}}. {{$productOrderCtrl.translations['antibody.pdp.commerceCard.promotion.learnmore']}}
产品信息
21028-1-AP
种属反应
宿主/亚型
分类
类型
抗原
偶联物
形式
浓度
规格
纯化类型
保存液
内含物
保存条件
运输条件
产品详细信息
Immunogen sequence: TDLDLDTEF EILLPRRRGL GLCATALVSY LIRLHNEIVY AVEKLSKENN SYSVDAAEVT ELHVISYEVE RDLTPLILSN CQYQVEEGRE TVQEFDLEKI QRQIVSRFLQ GKPRLSLKGI PTLVYRHDWN YEHLFMDIKN KMAQDSLPSS VISAISGQLQ SYSDACEVLS VVEVTLGFLS TAGGDPNMQL NVYTQDILQM GDQTIHVLKA LNRCQLKHTI ALWQFLSAHK SEQLLRLHKE PFGEISSRYK ADLSPENAKL LSTFLNQTGL DAFLLELHEM IILKLKNPQT QTEERFRPQW SLRDTLVSYM QTKESEILPE MASQFPEEIL LASCVSVWKT AAVLKWNREM R (4858-5207 aa encoded by BC032220)
靶标信息
RNF213 is an E3 ubiquitin-protein ligase involved in angiogenesis. Involved in the non-canonical Wnt signaling pathway in vascular development: acts by mediating ubiquitination and degradation of FLNA and NFATC2 downstream of RSPO3, leading to inhibit the non-canonical Wnt signaling pathway and promoting vessel regression. Also has ATPase activity.
仅用于科研。不用于诊断过程。未经明确授权不得转售。
生物信息学
蛋白别名: ALK lymphoma oligomerization on chromosome 17; ALK lymphoma oligomerization partner on chromosome 17; E3 ubiquitin-lipopolysaccharide ligase RNF213; E3 ubiquitin-protein ligase RNF213; Mysterin; RING finger protein 213; RING-type E3 ubiquitin transferase RNF213; unnamed protein product
基因别名: ALO17; C17orf27; KIAA1554; KIAA1618; MYMY2; MYSTR; NET57; RNF213
UniProt ID: (Human) Q63HN8
Entrez Gene ID: (Human) 57674